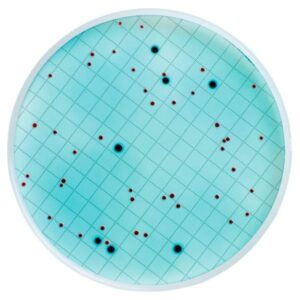
Deteksi total coliform, Coliform Detection Medium, Merck, 50 Test

Basic chemicals - Laboratory and technical grade
Showing 373–384 of 560 results
-

Cyanuric Chloride, 2,4,6-Trichloro-1,3,5-triazine, TCT, LAB, 1 gram
Rp12,900.0 Add to cart -

Cyclohexanone Oxime, N-Hydroxycyclohexanimine, LAB, 1 gram
Rp29,700.0 Add to cart -

Cyclohexylamine, Aminocyclohexane, Hexahydroaniline, LAB, 1 gram
Rp12,300.0 Add to cart -

Cyclohexylamine, Aminocyclohexane, Merck, 2.5 L
Rp2,213,200.0 Add to cart -

Damar Akrilik, Thermoplastic Acrylic Resin for Coating, 1 kg
Rp175,900.0 Add to cart -

Damar Minyak Bumi, Hydrocarbon Binder, Petroleum Resin (C9), 1 kg
Rp85,500.0 Add to cart -

Decon 90 (Liquid Concentrate Cleaning Agent), 5 Liter
Rp1,764,400.0 Add to cart -

Dekstrin, Dextrin, AR, 1 gram
Rp3,600.0 Add to cart -

Dess–Martin periodinane, Oxo-benziodoxoletriyl triacetate, LAB, 1 g
Rp260,200.0 Add to cart -
Deteksi total coliform, Coliform Detection Medium, Merck, 50 Test
Rp4,894,800.0 Add to cart -

Di amonium Oksalat, Di ammonium Oxalate Monohydrate, AR, 1 gram
Rp3,700.0 Add to cart -

di-Amonium hidrogen fosfat, Diammonium Hydrogen Phosphate AR, 1 gram
Rp3,600.0 Add to cart

